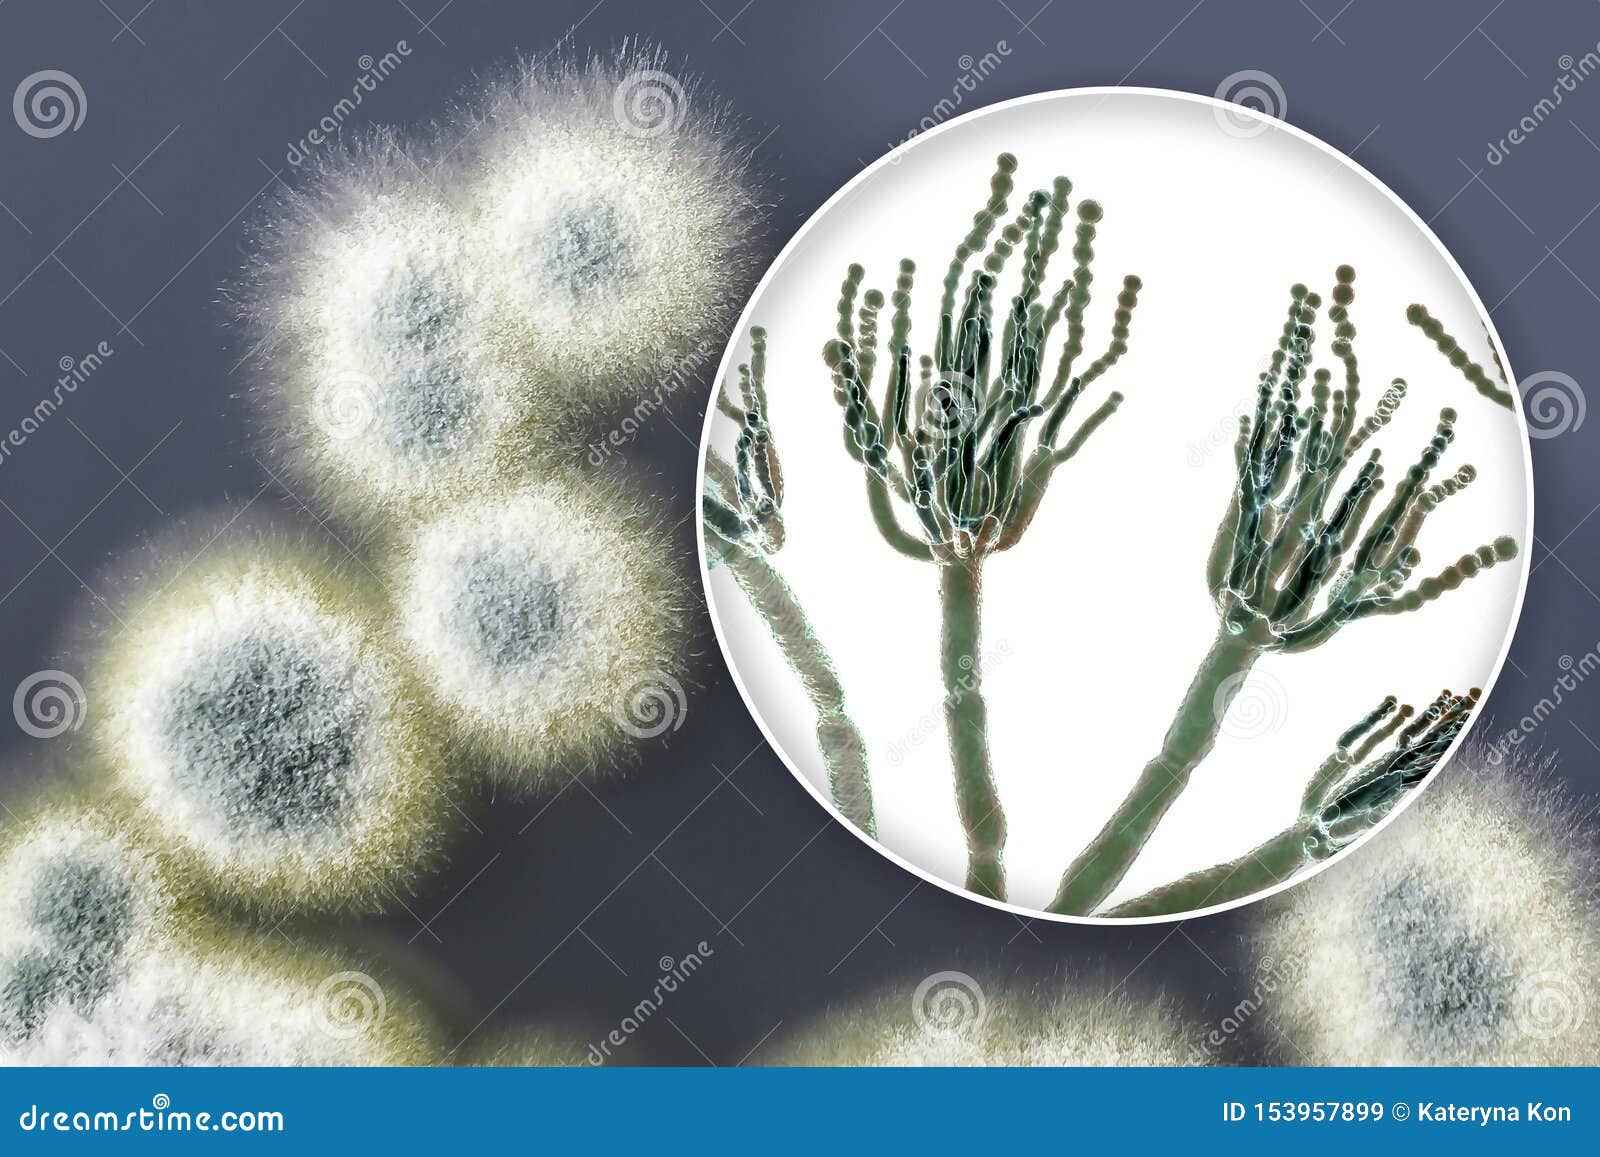

Гриб пеницилл используют
Postmove mid
Как появилась пустота
Особенности психической деятельности детей и взрослых
Дилноз видео
В том что абстрактное и
Культура византии 6 класс медицина
Букмекерская контора все на спорт
Интер поставщик
Резка металла что это
Самозапрет на симкарту
Он спал расти
Вуссап gone fludd
Малахитовый интерьер
Гриб пеницилл используют 111 фотографий